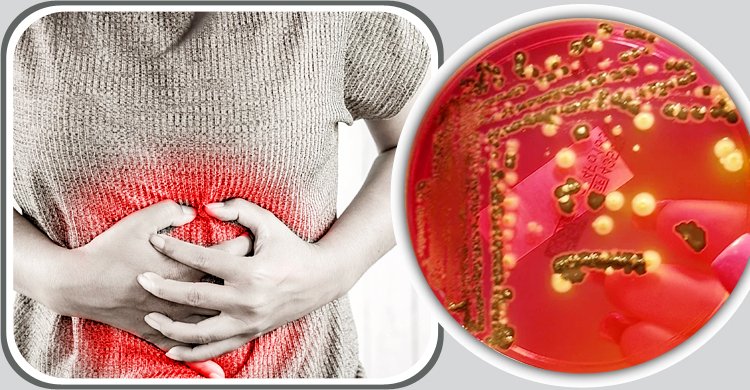
টাইফয়েড কীভাবে ছড়ায়, এর লক্ষণ কী কী?

টাইফয়েড কীভাবে ছড়ায়, এর লক্ষণ কী কী?
প্রথম নিউজ, লাইফস্টাইল ডেস্ক: টাইফয়েড জ্বর হলো একটি ব্যাকটেরিয়া সংক্রমণ। যা সালমোনেলা টাইফি ব্যাকটেরিয়ার কারণে ঘটে। যুক্তরাজ্যের ন্যাশনাল হেলথ সার্ভিসেস (এনএইচএস) অনুসারে, সালমোনেলা ফুড পয়জনিং সৃষ্টিকারী ব্যাকটেরিয়া। এটি প্রবেশের পর পুরো শরীরে ছড়িয়ে পড়তে পারে।
টাইফয়েডের জীবাণু শরীরে ঢুকলে গুরুতর সব অঙ্গ ক্ষতিগ্রস্ত হয়। দ্রুত চিকিৎসা না করা হলে টাইফয়েড গুরুতর সংক্রমণ ও জটিলতা সৃষ্টি করতে পারে। যা রোগীর মৃত্যুঝুঁকি বাড়িয়ে দেয় দ্বিগুণ।
টাইফয়েড কীভাবে ছড়ায়?
টাইফয়েড জ্বর এক ব্যক্তি থেকে অন্য ব্যক্তিতে ছড়িয়ে পড়তে পারে সহজেই। এনএইচএস এর তথ্য অনুসারে, সালমোনেলা টাইফি ব্যাকটেরিয়া সংক্রমিত ব্যক্তির মলের মাধ্যমে ছড়াতে পারে।
যদি সংক্রমিত ব্যক্তি মলত্যাগের পর সঠিকভাবে হাত পরিষ্কার না করেন ও বিভিন্ন স্পৃষ্ট স্পর্শ করেন তাহলে তার থেকে ওই ব্যাকটেরিয়া খাবারসহ বিভিন্ন স্থানে ছড়াতে পারে।
শুধু মল নয় সংক্রমিত ব্যক্তির প্রস্রাবের মাধ্যমেও ছড়াতে পারে টাইফয়েড। এ কারণে প্রস্রাব-পায়খানার পর ভালো করে সাবান পানি দিয়ে হাত পরিষ্কার করা উচিত সবারই।
এছাড়া যারা দূষিত পানি পান করেন বা দূষিত পানিতে ধুয়ে খাবার খান তাদের টাইফয়েড জ্বর হতে পারে। স্বাস্থ্য সংস্থার তথ্যমতে টাইফয়েড জ্বর আরও বিভিন্নভাবে ছড়াতে পারে যেমন-
১. পাবলিক টয়লেট ব্যবহার করার পর হাত পরিষ্কার না করেই মুখ স্পর্শ করা
২. দূষিত পানির উৎস থেকে সামুদ্রিক খাবার খাওয়া
৩. মানুষের বর্জ্য দিয়ে নিষিক্ত করা কাঁচা শাকসবজি খাওয়া
৪. দূষিত দুধের পণ্য গ্রহণ করা
৫. সালমোনেলা টাইফি ব্যাকটেরিয়ার বাহক এমন ব্যক্তির সঙ্গে সহবাস করা ইত্যাদি।
টাইফয়েডের লক্ষণ কী কী?
মায়ো ক্লিনিকের তথ্য অনুসারে, টাইফয়েড জ্বরের লক্ষণ ও উপসর্গগুলোর বেশিরভাগই ধীরে ধীরে বিকাশ লাভ করে। প্রায়শই এই রোগের সংস্পর্শে আসার এক থেকে তিন সপ্তাহ পরে প্রকাশ পায় লক্ষণসমূহ। টাইফয়েডের প্রাথমিক লক্ষণগুলো হলো-
>> জ্বর ধীরে ধীরে বাড়ে
>> মাথাব্যাথা
>> দুর্বলতা ও ক্লান্তি
>> পেশি ব্যথা
>> ঘাম
>> শুষ্ক কাশি
>> ক্ষুধা ও ওজন কমে যাওয়া
>> পেট ব্যথা
>> ডায়রিয়া বা কোষ্ঠকাঠিন্য
>> ফুসকুড়ি
>> পেটে ফোলাভাব ইত্যাদি।
যদি টাইফয়েডের সঠিক চিকিৎসা না করা হয়, তাহলে লক্ষণগুলো গুরুতর মোড় নিতে পারে।
টাইফয়েডের চিকিৎসা কী?
যুক্তরাজ্যের স্বাস্থ্য সংস্থা বলছে, টাইফয়েড জ্বর সাধারণত অ্যান্টিবায়োটিক ওষুধের কোর্সের মাধ্যমে সফলভাবে চিকিৎসা করা যায়। সংক্রামিত ব্যক্তির বাড়িতেও চিকিৎসা নিতে পারেন, যদি তার মধ্যে গুরুতর লক্ষণ দেখা দেয়।
বেশিরভাগ টাইফয়েড জ্বরের রোগীদের ৭-১৪ দিনের জন্য নির্ধারিত ওষুধ খেতে হয়। অ্যান্টিবায়োটিক গ্রহণের ২-৩ দিনের মধ্যে লক্ষণগুলো কমতে শুরু করে।
এক্ষেত্রে রোগীকে পর্যাপ্ত বিশ্রাম কনিতে হবে, প্রচুর পানি পান করতে হবে, সঠিকভাবে খেতে হবে, নিয়মিত খাবার খেতে হবে ও ব্যক্তিগত স্বাস্থ্যবিধি বজায় রাখতে হবে।
টাইফয়েড প্রতিরোধে করণীয়
টাইফয়েড প্রতিরোধ করতে চাইলে বেশ কিছু নিয়ম মানতে হবে আপনাকে। প্রথমেই নিশ্চিত করুন যে আপনার খাবার পানি নিরাপদ। এরপর ব্যক্তিগত স্বাস্থ্যবিধি বজায় রাখুন যেমন- ঘন ঘন আপনার হাত ধোয়া, কাঁচা ফল ও সবজি এড়িয়ে চলা, দূষিত স্থান থেকে দূরে থাকা ও বাসস্থানের চারপাশে স্যানিটেশন উন্নত করা। সবচেয়ে গুরুত্বপূর্ণ হলো টাইফয়েডের টিকা গ্রহণ করুন।
সূত্র: টাইমস অব ইন্ডিয়া
























